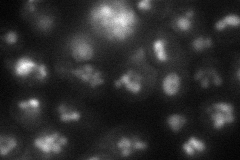
YLR443W
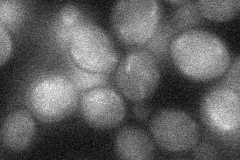
YLR443W
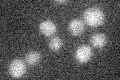
YLR443W

View description
Non-essential putative integral membrane protein; mutant has cell wall defects; transcription is induced under conditions of zinc deficiency
Localization:
Intensity:
Fold change:
Significance:
-
C’ GFP library in SD

below threshold16.36 -
N' NOP1pr-GFP in SD

ambiguous27.868 -
N' TEF2pr-mCherry in SD
vacuole27.766 -
N' NATIVEpr-GFP in SD

below threshold17.7787 -
N' TEF2pr-VC and Cyto-VN in SD
below threshold24.288 -
C’ GFP library in SD+DTT

cytosol14.830.9No -
C’ GFP library in SD+H2O2

cytosol16.821.02No -
C’ GFP library in Starvation Media
cytosol16.761.02No -
C’ GFP library on the background of Pup2-DaMP

below threshold -
C’ GFP library on the background of CCT mutant

below threshold16.76491.02405No
